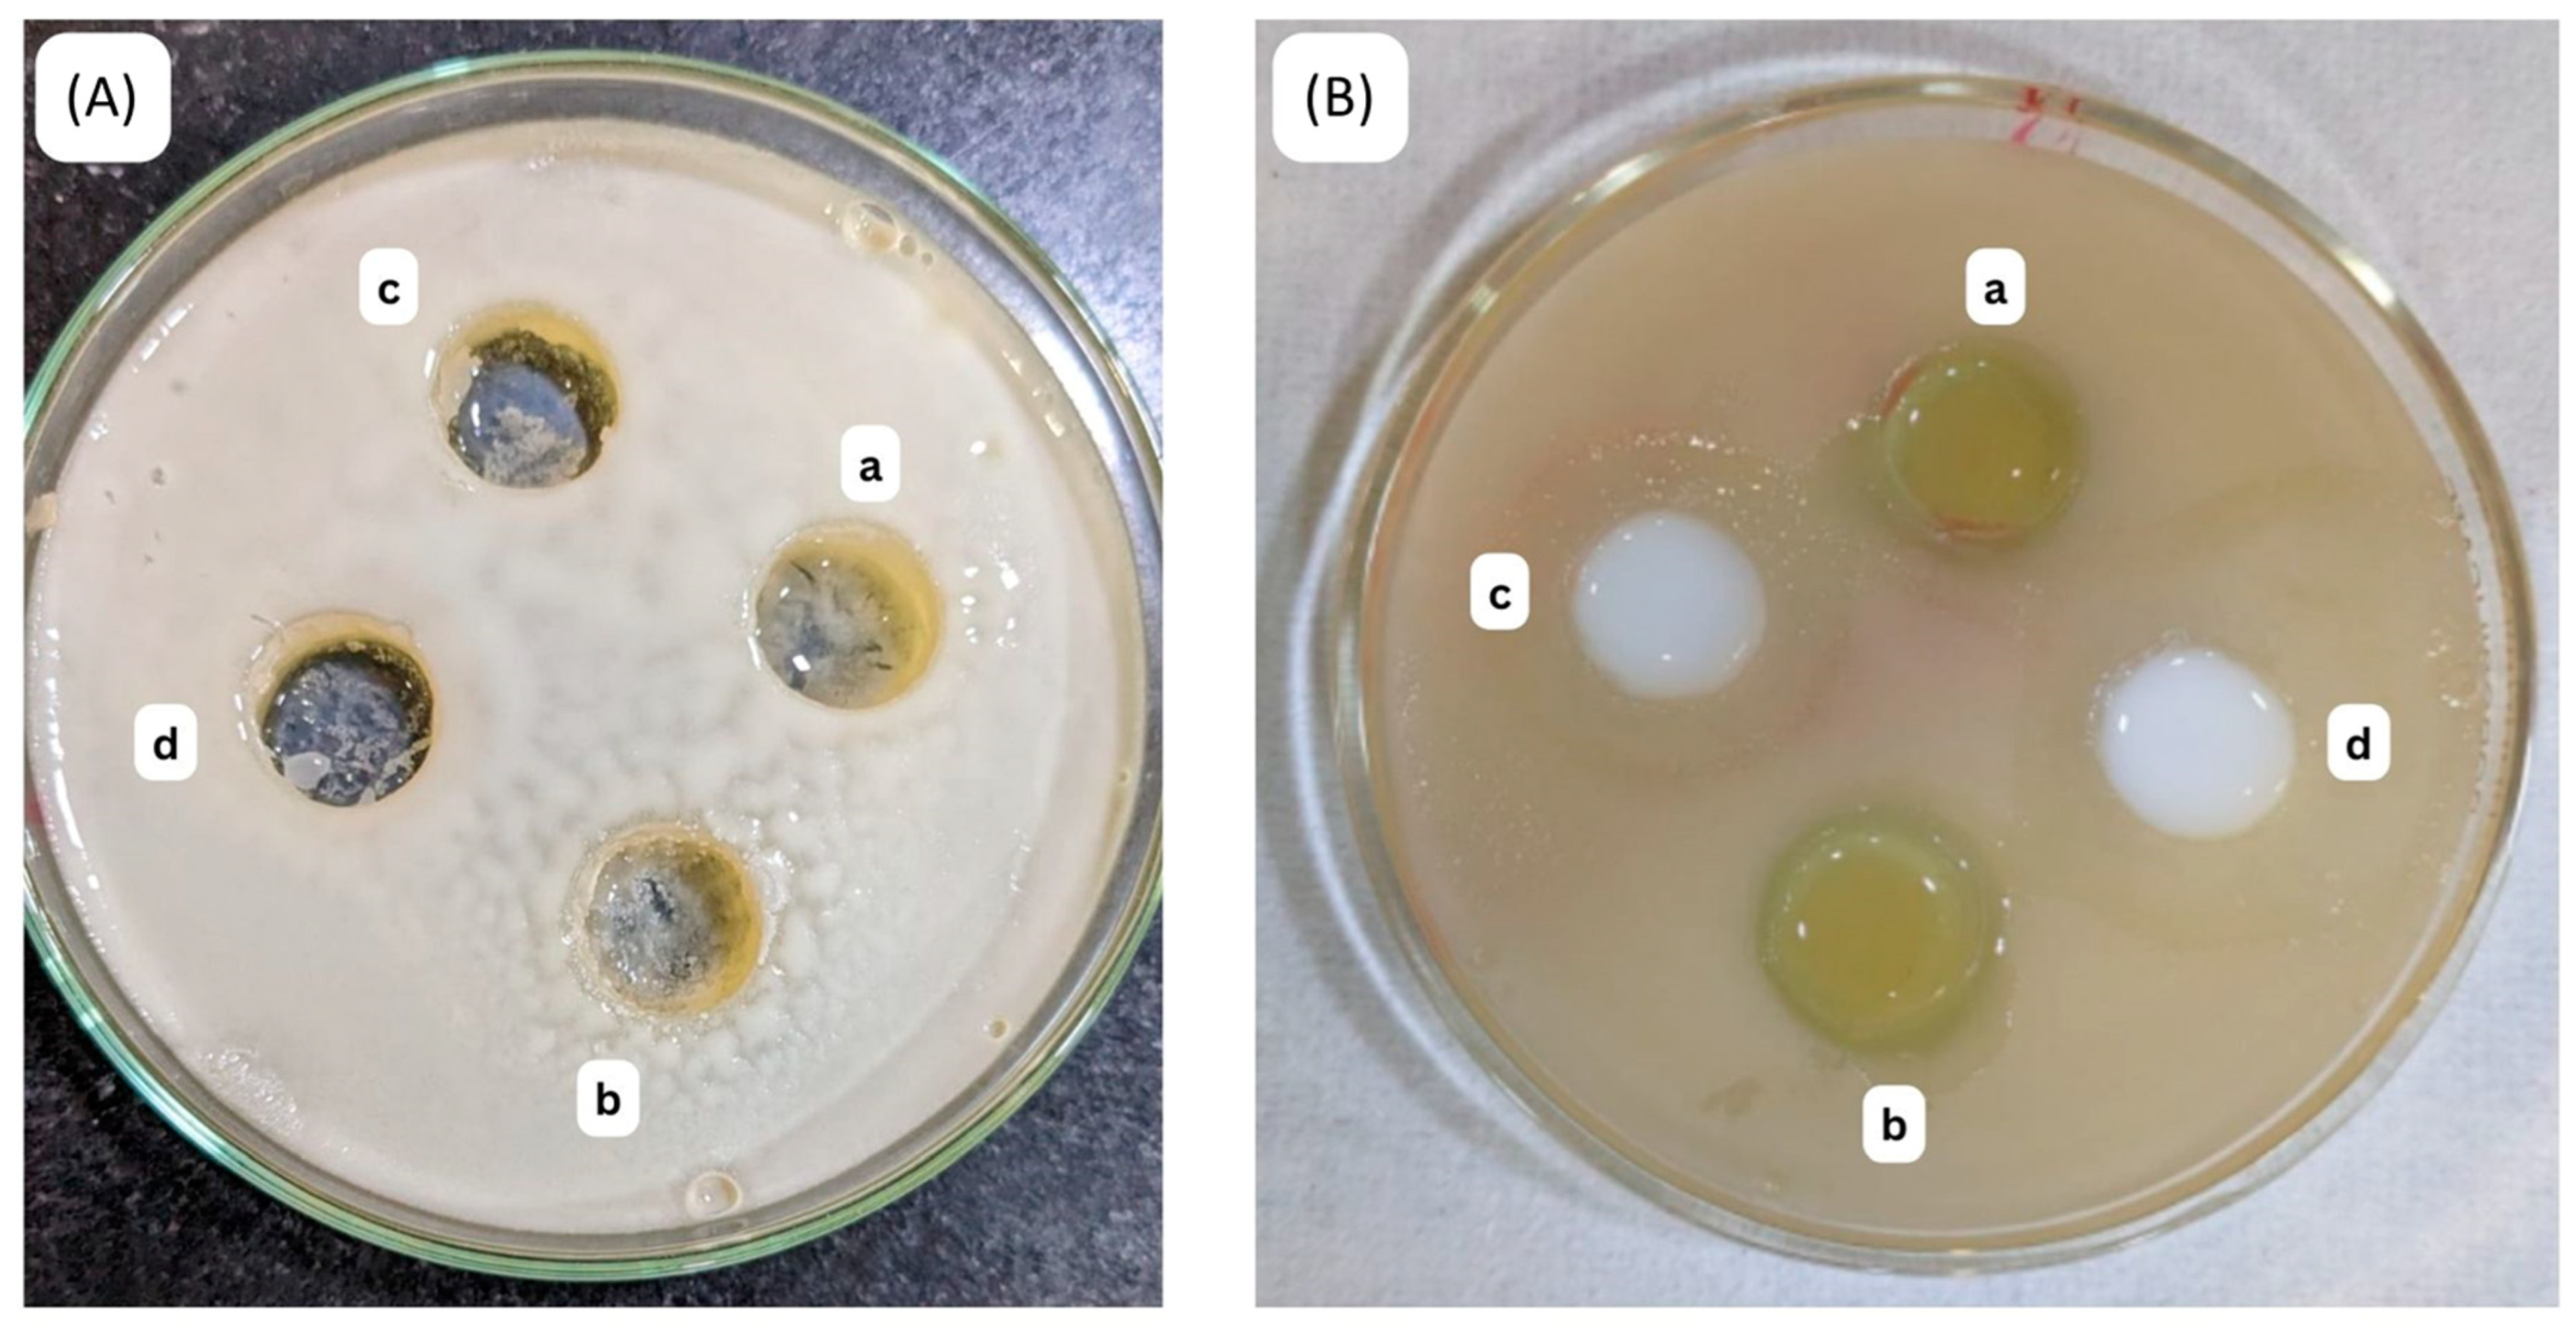
Gels 10 00303 g011

Cananga odorata (Ylang-Ylang) Essential Oil Containing Nanoemulgel for the Topical Treatment of Scalp Psoriasis and Dandruff
Abstract
:1. Introduction
2. Results and Discussion
2.1. Phytochemical Screening of C. odorata Oil
2.2. Pseudoternary Phase Behavior of Nanoemulsion (NE)
2.3. Characterization Study
2.4. Morphology of NE
2.5. Physical Stability Tests and Rheological Parameters
2.6. In Vivo Studies
2.7. Dermatokinetic Study
2.8. CCRD Studies
2.9. Effect of Variables on Particle Size
2.10. Effect of Variables on EE%
2.11. Effect of Variables on Zeta Size
2.12. Depth of Permeation
2.13. In Vitro Release Studies
2.14. DPPH Scavenging Activity of C. odorata NE
2.15. Antibacterial Activity
Minimum Inhibition Concentration and Minimum Bactericidal Concentration
3. Conclusions
4. Materials and Methods
4.1. Materials
4.2. Preparation of Hydroalcoholic Extract of C. odorata
4.3. Phytochemical Screening of Hydroalcoholic Extract of C. odorata
4.3.1. Analysis of Alkaloids
4.3.2. Analysis of Amino Acids
4.3.3. Analysis of Anthraquinone Glycosides
4.3.4. Analysis of Glycosides
4.3.5. Analysis of Phenolic Compounds and Tannins
4.3.6. Analysis of Flavonoids
4.3.7. Analysis of Gums and Mucilage
4.3.8. Analysis of Proteins
4.3.9. Analysis of Volatile Oils
4.4. Solubility of C. odorata Oil
4.5. NE Formulation
4.6. Particle Size Analysis
4.7. Morphology
4.8. Rheological Characteristics
4.9. Conductivity and pH Measurements
4.10. Physical Stability Tests
4.11. Animal Study Design
4.12. Skin Irritation Test
4.13. Skin Sebum Measurement
4.14. Skin Moisture Measurement
4.15. Skin Erythema Measurement
4.16. In Vitro Release Studies
4.17. Dermatokinetic Studies
4.18. Depth of Permeation
4.19. DPPH Radical Scavenging Activity of C. odorata Oil Nanoemulgel
4.20. Antimicrobial Activity
4.20.1. Inoculation Preparation for Antibacterial Activity
4.20.2. Antifungal Activity
4.21. Statistical Analysis
Author Contributions
Funding
Institutional Review Board Statement
Informed Consent Statement
Data Availability Statement
Acknowledgments
Conflicts of Interest
References
- Globe, D.; Bayliss, M.S.; Harrison, D.J. The impact of itch symptoms in psoriasis: Results from physician interviews and patient focus groups. Heal. Qual. Life Outcomes 2009, 7, 62. [Google Scholar] [CrossRef] [PubMed]
- AlQassimi, S.; AlBrashdi, S.; Galadari, H.; Hashim, M.J. Global burden of psoriasis—Comparison of regional and global epidemiology, 1990 to 2017. Int. J. Dermatol. 2020, 59, 566–571. Available online: https://onlinelibrary.wiley.com/doi/full/10.1111/ijd.14864 (accessed on 25 March 2024). [PubMed]
- Gary, G. Optimizing treatment approaches in seborrheic dermatitis. J. Clin. Aesthet. Dermatol. 2013, 6, 44–49. [Google Scholar]
- Imran, M.; Riaz, T.; Majid, H.; Maqsood, S. Identification of botanicals using molecular biotechnology. Polym. Med. 2023, 53, 69–79. [Google Scholar] [CrossRef]
- Tan, L.T.H.; Lee, L.H.; Yin, W.F.; Chan, C.K.; Abdul Kadir, H.; Chan, K.G.; Goh, B.H. Traditional Uses, Phytochemistry, and Bioactivities of C. odorata (Ylang-Ylang). Evid. -Based Complement. Altern. Med. 2015, 2015, 896314. [Google Scholar] [CrossRef]
- Guzmán, E.; Lucia, A. Essential Oils and Their Individual Components in Cosmetic Products. Cosmetics 2021, 8, 114. [Google Scholar] [CrossRef]
- Singh, Y.; Meher, J.G.; Raval, K.; Khan, F.A.; Chaurasia, M.; Jain, N.K.; Chourasia, M.K. Nanoemulsion: Concepts, development and applications in drug delivery. J. Control. Release 2017, 252, 28–49. [Google Scholar] [CrossRef]
- Escuin-Ordinas, H.; Liu, Y.; Sun, L.; Hugo, W.; Dimatteo, R.; Huang, R.R.; Krystofinski, P.; Azhdam, A.; Lee, J.; Comin-Anduix, B.; et al. Wound healing with topical BRAF inhibitor therapy in a diabetic model suggests tissue regenerative effects. PLoS ONE 2021, 16, e0252597. Available online: https://journals.plos.org/plosone/article?id=10.1371/journal.pone.0252597 (accessed on 25 July 2022). [CrossRef] [PubMed]
- Zuo, X.; Shi, X.; Zhang, X.; Chen, Z.; Yang, Z.; Pan, X.; Lai, R.; Zhao, Z. Postoperative Ileus with the Topical Application of Tongfu Decoction Based on Network Pharmacology and Experimental Validation. Evid. Based Complement. Altern. Med. 2022, 2022, 2347419. [Google Scholar] [CrossRef]
- Karhana, S.; Dabral, S.; Garg, A.; Bano, A.; Agarwal, N.; Khan, M.A. Network pharmacology and molecular docking analysis on potential molecular targets and mechanism of action of BRAF inhibitors for application in wound healing. J. Cell. Biochem. 2023, 124, 1023–1039. [Google Scholar] [CrossRef]
- Chu, M.; Tsang, M.S.-M.; He, R.; Lam, C.W.-K.; Quan, Z.B.; Wong, C.K. The Active Compounds and Therapeutic Mechanisms of Pentaherbs Formula for Oral and Topical Treatment of Atopic Dermatitis Based on Network Pharmacology. Plants 2020, 9, 1166. [Google Scholar] [CrossRef]
- Rice, S.B.; Chan, C.; Brown, S.C.; Eschbach, P.; Han, L.; Ensor, D.S.; Stefaniak, A.B.; Bonevich, J.; E Vladár, A.; Walker, A.R.H.; et al. Particle size distributions by transmission electron microscopy: An interlaboratory comparison case study. Metrologia 2013, 50, 663–678. [Google Scholar] [CrossRef] [PubMed]
- Van Bocxlaer, K.; Yardley, V.; Murdan, S.; Croft, S.L. Drug permeation and barrier damage in Leishmania -infected mouse skin. J. Antimicrob. Chemother. 2016, 71, 1578–1585. [Google Scholar] [CrossRef] [PubMed]
- Danby, S.G.; Andrew, P.V.; Kay, L.J.; Pinnock, A.; Chittock, J.; Brown, K.; Williams, S.F.; Cork, M.J. Enhancement of stratum corneum lipid structure improves skin barrier function and protects against irritation in adults with dry, eczema-prone skin*. Br. J. Dermatol. 2022, 186, 875–886. [Google Scholar] [CrossRef] [PubMed]
- Jiea, C.K.; Fuloria, S.; Subrimanyan, V.; Sekar, M.; Sathasivam, K.V.; Kayarohanam, S.; Wu, Y.S.; Velaga, V.S.S.R.; Janakiraman, A.K.; Maziz, M.N.H.; et al. Phytochemical screening and Antioxidant activity of C. odorata extract. Res. J. Pharm. Technol. 2022, 15, 1230–1234. [Google Scholar] [CrossRef]
- Kale, S. Screening of Phytochemical Components of Leaf Extracts. Int. J. Curr. Microbiol. Appl. Sci. 2020, 9, 2394–2401. [Google Scholar] [CrossRef]
- Phytochemical Investigation of Extract/Solvent Fractions of Piper Nigrum Linn. Seeds and Piper Betle Linn. Leaves [Internet]. Available online: https://www.researchgate.net/publication/288103488_Phytochemical_investigation_of_extractsolvent_fractions_of_Piper_nigrum_Linn_Seeds_and_Piper_betle_Linn_leaves (accessed on 25 March 2024).
- Zohra, S.F.; Meriem, B.; Samira, S.; Muneer, M.A. Phytochemical Screening and identification of some compounds from Mallow. J. Nat. Prod. Plant Resour. 2012, 2, 512–516. Available online: http://scholarsresearchlibrary.com/archive.html (accessed on 25 March 2024).
- Korwar, P.G.; Beknal, A.K.; Patil, B.S.; Halkai, M.A.; Kulkarni, U.; Hariprasanna, R.C.; Soodam, S.R. A study on phytochemical investigation of Drynaria quercifolia linn rhizome. 2010, 1, 148–158. Available online: www.ijpsr.com (accessed on 25 March 2024).
- Deshpande, S.N.; Kadam, D.G. Preliminary phytochemical analysis of some medicinal plants. DAV Int. J. Sci. 2013, 2, 2277–5641. [Google Scholar]
- Njoku, O. Applied COA Journal of Pure and, 2009 Undefined. Phytochemical Constituents of Some Selected Medicinal Plants. academicjournals.org [Internet]. Available online: https://academicjournals.org/journal/AJPAC/article-full-text-pdf/E9904441929/1000 (accessed on 25 March 2024).
- Feda, D.A.L.O.; Yener, F.G.; Altuntaş, E.; Döşler, S. A Cosmetic Nanoemulsion Against Seborrheic Dermatitis: Development, Characterization and Effectiveness. Fabad J. Pharm. Sci. 2022, 47, 213–230. [Google Scholar]
- Wu, W.; He, W.; Tan, Y.; Tian, Z.; Chen, L.; Hu, F.-Q. Food protein-stabilized nanoemulsions as potential delivery systems for poorly water-soluble drugs: Preparation, in vitro characterization, and pharmacokinetics in rats. Int. J. Nanomed. 2011, 6, 521–533. [Google Scholar] [CrossRef]
- Rebolleda, S.; Sanz, M.T.; Benito, J.M.; Beltrán, S.; Escudero, I.; San-José, M.L.G. Formulation and characterisation of wheat bran oil-in-water nanoemulsions. Food Chem. 2015, 167, 16–23. [Google Scholar] [CrossRef] [PubMed]
- Chen, L.; Doyle, P.S. Design and Use of a Thermogelling Methylcellulose Nanoemulsion to Formulate Nanocrystalline Oral Dosage Forms. Adv. Mater. 2021, 33, 2008618. [Google Scholar] [CrossRef] [PubMed]
- Shakeel, F.; Ramadan, W.; Ahmed, M.A. Investigation of true nanoemulsions for transdermal potential of indomethacin: Characterization, rheological characteristics, and ex vivo skin permeation studies. J. Drug Target. 2009, 17, 435–441. [Google Scholar] [CrossRef] [PubMed]
- Altuntaş, E.; Yener, G. Anti-aging potential of a cream containing herbal oils and honey: Formulation and in vivo evaluation of effectiveness using non-invasive biophysical techniques. J. Pharm. Biol. Sci. 2015, 10, 51–60. [Google Scholar]
- Qadir, A.; Faiyazuddin; Hussain, T.; Alshammari, T.M.; Shakeel, F. Critical steps and energetics involved in a successful development of a stable nanoemulsion. J. Mol. Liq. 2016, 214, 7–18. [Google Scholar] [CrossRef]
- Valizadeh, A.; Shirzad, M.; Pourmand, M.R.; Farahmandfar, M.; Sereshti, H.; Amani, A. Levofloxacin nanoemulsion gel has a powerful healing effect on infected wound in streptozotocin-induced diabetic rats. Drug Deliv. Transl. Res. 2021, 11, 292–304. [Google Scholar] [CrossRef] [PubMed]
- Zhengguang, L.; Jie, H.; Yong, Z.; Jiaojiao, C.; Xingqi, W.; Xiaoqin, C. Study on the transdermal penetration mechanism of ibuprofen nanoemulsions. Drug Dev. Ind. Pharm. 2019, 45, 465–473. [Google Scholar] [CrossRef] [PubMed]
- Zhou, H.; Yue, Y.; Liu, G.; Li, Y.; Zhang, J.; Gong, Q.; Yan, Z.; Duan, M. Preparation and Characterization of a Lecithin Nanoemulsion as a Topical Delivery System. Nanoscale Res. Lett. 2010, 5, 224. [Google Scholar] [CrossRef] [PubMed]
- Shakeel, F.; Shafiq, S.; Haq, N.; Alanazi, F.K.; A Alsarra, I. Nanoemulsions as potential vehicles for transdermal and dermal delivery of hydrophobic compounds: An overview. Expert Opin. Drug Deliv. 2012, 9, 953–974. [Google Scholar] [CrossRef]
- Bostancı, N.S.; Büyüksungur, S.; Hasirci, N.; Tezcaner, A. pH responsive release of curcumin from photocrosslinked pectin/gelatin hydrogel wound dressings. Biomater. Adv. 2022, 134, 112717. [Google Scholar] [CrossRef]
- Kumar, M.; Sharma, A.; Mahmood, S.; Thakur, A.; Mirza, M.A.; Bhatia, A. Franz diffusion cell and its implication in skin permeation studies. J. Dispers. Sci. Technol. 2023, 45, 943–956. [Google Scholar] [CrossRef]
- Negi, P.; Singh, B.; Sharma, G.; Beg, S.; Katare, O.P. Biocompatible lidocaine and prilocaine loaded-nanoemulsion system for enhanced percutaneous absorption: QbD-based optimisation, dermatokinetics and in vivo evaluation. J. Microencapsul. 2015, 32, 1464–5246. Available online: http://informahealthcare.com/mnc (accessed on 25 March 2024). [CrossRef] [PubMed]
- Iqbal, B.; Ali, J.; Baboota, S. Silymarin loaded nanostructured lipid carrier: From design and dermatokinetic study to mechanistic analysis of epidermal drug deposition enhancement. J. Mol. Liq. 2018, 255, 513–529. [Google Scholar] [CrossRef]
- Morteza-Semnani, K.; Saeedi, M.; Akbari, J.; Eghbali, M.; Babaei, A.; Hashemi, S.M.H.; Nokhodchi, A. Development of a Novel Nanoemulgel Formulation Containing Cumin Essential Oil as Skin Permeation Enhancer. Drug Deliv. Transl. Res. 2022, 12, 1455–1465. [Google Scholar] [PubMed]
- Imran, M.; Khan, A.S.; Khan, M.A.; Saeed, M.U.; Noor, N.; Warsi, M.H.; Qadir, A. Antimicrobial activity of different plants extracts against Staphylococcus aureus and Escherichia coli. Polym. Med. 2021, 51, 69–75. Available online: https://pubmed.ncbi.nlm.nih.gov/34783203/ (accessed on 25 March 2024). [CrossRef] [PubMed]
- Pinto, E.; Vale-Silva, L.; Cavaleiro, C.; Salgueiro, L. Antifungal Activity of the Clove Essential Oil from Syzygium Aromaticum on Candida, Aspergillus and Dermatophyte Species. Available online: www.microbiologyresearch.org (accessed on 25 March 2024).
- Alam, P.; Imran, M.; Ahmed, S.; Majid, H.; Akhtar, A. Chitosan Nanoparticles for Enhanced Delivery of Sida cordifolia Extract: Formulation, Optimization and Bioactivity Assessment. Pharmaceuticals 2023, 16, 1561. [Google Scholar] [CrossRef] [PubMed]
- Wilson, R.J.; Li, Y.; Yang, G.; Zhao, C.X. Nanoemulsions for drug delivery. Particuology 2022, 64, 85–97. [Google Scholar] [CrossRef]
- Jaiswal, M.; Dudhe, R.; Sharma, P.K. Nanoemulsion: An advanced mode of drug delivery system. 3 Biotech 2015, 5, 123. Available online: https://pubmed.ncbi.nlm.nih.gov/28324579/ (accessed on 2 March 2024). [CrossRef] [PubMed]
- Marzuki, N.H.C.; Wahab, R.A.; Hamid, M.A. An overview of nanoemulsion: Concepts of development and cosmeceutical applications. Biotechnol. Biotechnol. Equip. 2019, 33, 779–797. Available online: https://www.tandfonline.com/doi/abs/10.1080/13102818.2019.1620124 (accessed on 2 March 2024). [CrossRef]
- Sneha, K.; Kumar, A. Nanoemulsions: Techniques for the preparation and the recent advances in their food applications. Innov. Food Sci. Emerg. Technol. 2022, 76, 102914. [Google Scholar]
- Mosqueira, V.C.F.; Legrand, P.; Pinto-Alphandary, H.; Puisieux, F.; Barratt, G. Poly(D,L-Lactide) Nanocapsules Prepared by a Solvent Displacement Process: Influence of the Composition on Physicochemical and Structural Properties. J. Pharm. Sci. 2000, 89, 614–626. [Google Scholar] [CrossRef]
- Li, L.; He, M.; Fang, C.; Zhang, Y.; Wang, Y.; Song, X.; Zou, Y.; Jia, R.; Liang, X.; Yin, L.; et al. Preparation, characterization, ex vivo transdermal properties and skin irritation evaluation of 1,8-cineole nanoemulsion gel. Int. J. Pharm. 2022, 624, 121982. [Google Scholar] [CrossRef] [PubMed]
- Pavoni, L.; Perinelli, D.R.; Bonacucina, G.; Cespi, M.; Palmieri, G.F. An Overview of Micro- and Nanoemulsions as Vehicles for Essential Oils: Formulation, Preparation and Stability. Nanomaterials 2020, 10, 135. [Google Scholar] [CrossRef] [PubMed]
- Boer, M.; Duchnik, E.; Maleszka, R.; Marchlewicz, M. Structural and biophysical characteristics of human skin in maintaining proper epidermal barrier function. Adv. Dermatol. Allergol. 2016, 1, 1–5. [Google Scholar] [CrossRef] [PubMed]
- Lukić, M.; Pantelić, I.; Savić, S.D. Towards Optimal pH of the Skin and Topical Formulations: From the Current State of the Art to Tailored Products. Cosmetics 2021, 8, 69. [Google Scholar] [CrossRef]
- Lu, T.; Ten Hagen, T.L. A novel kinetic model to describe the ultra-fast triggered release of thermosensitive liposomal drug delivery systems. J. Control. Release 2020, 324, 669–678. [Google Scholar] [CrossRef] [PubMed]
- Santadkha, T.; Skolpap, W.; Thitapakorn, V. Diffusion Modeling and In Vitro Release Kinetics Studies of Curcumin−Loaded Superparamagnetic Nanomicelles in Cancer Drug Delivery System. J. Pharm. Sci. 2022, 111, 1690–1699. [Google Scholar] [CrossRef]
- Sundar, S.; Parikh, J.K. Advances and trends in encapsulation of essential oils. Int. J. Pharm. 2023, 635, 122668. [Google Scholar] [CrossRef]
- Pathania, R.; Khan, H.; Kaushik, R.; Khan, M.A. Essential Oil Nanoemulsions and their Antimicrobial and Food Applications. Curr. Res. Nutr. Food Sci. J. 2018, 6, 626–643. [Google Scholar] [CrossRef]

| Phytochemical Test | C. odorata Hydroalcoholic Extract | Name of Test | Observation | Inference | Reference |
|---|---|---|---|---|---|
| Alkaloids | Present | Dragendorff’s Test | Yellow precipitate | Presence of alkaloids | [18] |
| Amino Acids | Absent | Ninhydrin Test | - | Absence of amino acids | [19] |
| Anthraquinone Glycosides | Present | Bornträger’s Test | Pink to red color | Presence of glycosides | [20] |
| Carbohydrates | Present | Molisch’s Test | Brick-red precipitate | Presence of carbohydrates | [19] |
| Coumarin Glycosides | Absent | Sodium Hydroxide Test | - | Absence of coumarin glycosides | [18] |
| Flavonoids | Present | Ammonia Test | Yellow coloration | Presence of flavonoids | [18] |
| Gums and Mucilage | Present | Ruthenium Red Test | Viscous consistency | Presence of mucilage | [21] |
| Phenolic Compounds | Present | Ferric Chloride Test | Greenish-black color | Presence of phenolic compounds | [18] |
| Tannins | Present | Lead Acetate Test | Brownish-green precipitate | Presence of tannins | [18] |
| Proteins | Absent | Biuret Test | - | Absence of proteins | [22] |
| Volatile Oils | Present | Steam Distillation Test | Aromatic smell | Presence of volatile oils | [23] |
| Temperature | Time | Droplet Size (nm) | Polydispersity Index (PDI) | Zeta Potential (mV) | pH | Conductivity (µs/cm) |
|---|---|---|---|---|---|---|
| 5 °C | T30 | 172 ± 2.13 | 0.1350 ± 0.01 | −18.36 ± 0.79 | 4.78 ± 0.02 | 81.05 ± 1.34 |
| T60 | 187 ± 1.17 | 0.1395 ± 0.04 | −19.85 ± 0.67 | 5.03 ± 0.01 | 85.06 ± 2.89 | |
| T90 | 185 ± 2.09 | 0.1640 ± 0.05 | −20.45 ± 0.89 | 4.95 ± 0.09 | 89.09 ± 1.89 | |
| T180 | 184 ± 1.12 | 0.1840 ± 0.01 | −21.14 ± 0.42 | 4.51 ± 0.01 | 88.28 ± 1.67 | |
| 25 °C | T30 | 179 ± 2.17 | 0.1786 ± 0.10 | −18.99 ± 1.84 | 5.08 ± 0.01 | 95.02 ± 1.07 |
| T60 | 190 ± 2.07 | 0.1367 ± 0.06 | −19.45 ± 0.98 | 4.55 ± 0.02 | 101.78 ± 1.97 | |
| T90 | 188 ± 1.90 | 0.1479 ± 0.05 | −19.67 ± 1. 45 | 4.89 ± 0.03 | 128.05 ± 1.67 | |
| T180 | 188 ± 0.30 | 0.1392 ± 0.20 | −19.32 ± 1. 15 | 4.10 ± 0.08 | 127.15 ± 1.03 | |
| 40 °C | T30 | 189 ± 0.79 | 0.1579 ± 0.01 | −20.45 ± 0.73 | 4.78 ± 0.01 | 106.64 ± 1.45 |
| T60 | 183 ± 2.67 | 0.1802 ± 0.06 | −18.96 ± 1.23 | 4.86 ± 0.03 | 109.04 ± 2.78 | |
| T90 | 192 ± 0.50 | 0.1600 ± 0.03 | −19.43 ± 0.67 | 5.08 ± 0.01 | 90.68 ± 2.35 | |
| T180 | 191 ± 0.67 | 0.1720 ± 0.38 | −18.91 ± 0.53 | 5.18 ± 0.23 | 91.13 ± 2.11 |
| Speed (rpm) | Viscosity (cP) | ||||||
|---|---|---|---|---|---|---|---|
| T1 | T30 | T60 | |||||
| 25 °C | 4 °C | 25 °C | 40 °C | 4 °C | 25 °C | 40 °C | |
| 70 | 6.79 ± 0.11 | 6.98 ± 0.01 | 6.78 ± 0.19 | 6.39 ± 0.09 | 7.04 ± 0.61 | 6.78 ± 0.12 | 7.13 ± 0.12 |
| 75 | 6.90 ± 0.02 | 6.59 ± 0.9 | 6.39 ± 0.02 | 6.40 ± 0.13 | 6.93 ± 0.07 | 6.54 ± 0.98 | 6.57 ± 0.91 |
| 80 | 6.34 ± 0.01 | 7.01 ± 0.03 | 6.80 ± 0.21 | 6.20 ± 0.15 | 6.49 ± 0.02 | 7.06 ± 0.14 | 6.49 ± 0.13 |
| 85 | 6.56 ± 0.3 | 6.89 ± 0.01 | 6.50 ± 0.11 | 6.38 ± 0.16 | 6.29 ± 0.43 | 6.49 ± 0.12 | 6.48 ± 0.04 |
| 90 | 6.12 ± 0.12 | 6.49 ± 0.19 | 6.90 ± 0.13 | 6.56 ± 0.02 | 6.47 ± 0.51 | 7.12 ± 0.92 | 7.15 ± 0.65 |
| 95 | 6.33 ± 0.63 | 7.06 ± 0.21 | 7.09 ± 0.02 | 6.29 ± 0.08 | 6.39 ± 0.02 | 6.34 ± 0.71 | 6.73 ± 0.98 |
| 100 | 6.56 ± 0.09 | 6.91 ± 0.18 | 6.58 ± 0.13 | 6.49 ± 0.01 | 6.28 ± 0.92 | 6.48 ± 0.81 | 6.29 ± 0.93 |
| 105 | 6.92 ± 0.81 | 6.89 ± 0.12 | 7.04 ± 0.15 | 6.48 ± 0.03 | 6.45 ± 0. 83 | 6.70 ± 0.11 | 6.96 ± 0.12 |
| 110 | 6.76 ± 0.05 | 6.50 ± 0.1 | 6.75 ± 1.2 | 6.79 ± 0.19 | 6.38 ± 0.78 | 6.59 ± 0.18 | 6.52 ± 0.11 |
| Parameter | Before Treatment | After Treatment | p-Value |
|---|---|---|---|
| Skin pH | 5.5 ± 0.3 | 5.6 ± 0.1 | Not Assessed |
| Skin sebum content (mg/cm2) | 26.75 ± 14.05 | 5.67 ± 8.75 | 0.0453 |
| Skin hydration index (AU) * | 18.09 ± 15.07 | 41.28 ± 9.29 | 0.0232 |
| Skin erythema index (AU) * | 580 ± 39.09 | 520.32 ± 21.43 | <0.0001 |
| Std. | Run | Factor 1 | Factor 2 | Response 1 | Response 2 | Response 3 |
|---|---|---|---|---|---|---|
| A: C. odorata oil | B: Smix | Particle Size | Zeta Potential | EE | ||
| mL | nm | mV | % | |||
| 1 | 1 | 10 | 2 | 209.5 | −21.61 | 79.84 |
| 2 | 13 | 50 | 2 | 223.8 | −26.3 | 74.51 |
| 3 | 4 | 10 | 4 | 205.8 | −21.63 | 69.58 |
| 4 | 11 | 50 | 4 | 231.7 | −26.64 | 78.61 |
| 5 | 10 | 1.71573 | 3 | 195.6 | −18.81 | 80.14 |
| 6 | 6 | 58.2843 | 3 | 238.2 | −22.8 | 78.99 |
| 7 | 12 | 30 | 1.58579 | 210.5 | −27.92 | 71.54 |
| 8 | 7 | 30 | 4.41421 | 218.6 | −28.73 | 71.9 |
| 9 | 2 | 30 | 3 | 200.5 | −21.11 | 85.33 |
| 10 | 9 | 30 | 3 | 192.3 | −20.84 | 86.11 |
| 11 | 8 | 30 | 3 | 191.7 | −19.35 | 86.25 |
| 12 | 3 | 30 | 3 | 198.6 | −20.53 | 85.01 |
| 13 | 5 | 30 | 3 | 195.1 | −21.12 | 84.85 |
| Source | Sum of Squares | df | Mean Square | F-Value | p-Value | |
|---|---|---|---|---|---|---|
| (a) Response for particle size | ||||||
| Model | 2697.27 | 5 | 539.45 | 30.46 | 0.0001 | Significant |
| A: C. odorata Oil | 1261.16 | 1 | 1261.16 | 71.22 | <0.0001 | |
| B: Smix | 30.64 | 1 | 30.64 | 1.73 | 0.2299 | |
| AB | 33.64 | 1 | 33.64 | 1.90 | 0.2106 | |
| A² | 860.78 | 1 | 860.78 | 48.61 | 0.0002 | |
| B² | 688.54 | 1 | 688.54 | 38.88 | 0.0004 | |
| Residual | 123.96 | 7 | 17.71 | |||
| Lack of Fit | 64.61 | 3 | 21.54 | 1.45 | 0.3535 | Not Significant |
| Pure Error | 59.35 | 4 | 14.84 | |||
| Cor Total | 2821.23 | 12 | ||||
| (b) Response for zeta potential | ||||||
| Model | 128.75 | 5 | 25.75 | 37.31 | <0.0001 | Significant |
| A: C. odorata | 29.42 | 1 | 29.42 | 42.64 | 0.0003 | |
| B: Smix | 0.2833 | 1 | 0.2833 | 0.4106 | 0.5421 | |
| AB | 0.0256 | 1 | 0.0256 | 0.0371 | 0.8527 | |
| A² | 0.0035 | 1 | 0.0035 | 0.0051 | 0.9450 | |
| B² | 97.18 | 1 | 97.18 | 140.82 | <0.0001 | |
| Residual | 4.83 | 7 | 0.6901 | |||
| Lack of Fit | 2.68 | 3 | 0.8919 | 1.66 | 0.3119 | Not Significant |
| Pure Error | 2.16 | 4 | 0.5388 | |||
| Cor Total | 133.58 | 12 | ||||
| (c) Response for entrapment efficiency | ||||||
| Model | 417.45 | 5 | 83.49 | 54.46 | <0.0001 | Significant |
| A: C. odorata | 0.5375 | 1 | 0.5375 | 0.3506 | 0.5724 | |
| B: Smix | 3.99 | 1 | 3.99 | 2.60 | 0.1507 | |
| AB | 51.55 | 1 | 51.55 | 33.63 | 0.0007 | |
| A² | 61.54 | 1 | 61.54 | 40.14 | 0.0004 | |
| B² | 330.90 | 1 | 330.90 | 215.84 | <0.0001 | |
| Residual | 10.73 | 7 | 1.53 | |||
| Lack of Fit | 9.11 | 3 | 3.04 | 7.47 | 0.0408 | Significant |
| Pure Error | 1.63 | 4 | 0.4064 | |||
| Cor Total | 428.18 | 12 | ||||
| No. | Sample Type | Concentration (µg/mL) | Percentage of Antioxidant Scavenging Activity Trial 1 | Percentage of Antioxidant Scavenging Activity Trial 2 | Percentage of Antioxidant Scavenging Activity Trial 3 | Mean ± SD |
|---|---|---|---|---|---|---|
| 1 | Ascorbic acid | 10 | 86.12 ± 1.19 | 87.10 ± 1.92 | 86.68 ± 0.91 | 86.63 ± 0.492 |
| 2 | Ascorbic acid | 30 | 88.91 ± 1.06 | 88.93 ± 1.26 | 88.72 ± 0.98 | 88.85 ± 0.116 |
| 3 | Ascorbic acid | 50 | 92.35 ± 0.23 | 92.31 ± 0.54 | 92.23 ± 1.92 | 92.30 ± 0.061 |
| 4 | C. odorata nanoemulgel | 10 | 7.98 ± 2.93 | 8.21 ± 0.12 | 8.22 ± 1.21 | 8.14 ± 0.136 |
| 5 | C. odorata nanoemulgel | 30 | 14.24 ± 1.26 | 14.31 ± 2.10 | 14.33 ± 1.24 | 14.29 ± 0.047 |
| 6 | C. odorata nanoemulgel | 50 | 47.45 ± 0.12 | 46.99 ± 0.19 | 46.98 ± 0.27 | 47.14 ± 0.269 |
| Formulation | Concentration (µg/mL) | Inhibition Zone (mm) | |
|---|---|---|---|
| E. coli | S. aureus | ||
| Hydroethanolic extract of C. odorata | 10 | 7.16 ± 0.17 | 9.56 ± 0.81 |
| C. odorata essential oil | 10 | 11.87 ± 0.19 | 13.64 ± 0.43 |
| C. odorata nanoemulgel | 10 | 15.18 ± 0.87 | 16.15 ± 0.24 |
| C. odorata nanoemulgel | 30 | 16.48 ± 0.23 | 18.23 ± 0.46 |
| C. odorata nanoemulgel | 50 | 21.32 ± 0.21 | 23.41 ± 0.72 |
| Ciprofloxacin | 250 | 18.65 ± 0.49 | 19.76 ± 0.21 |
| Formulation | Concentration (µg/mL) | Inhibition Zone (mm) | |
|---|---|---|---|
| Candida albicans | Aspergillus fumigatus | ||
| Hydroethanolic extract of C. odorata | 10 | 2.16 ± 0.14 | 2.14 ± 0.54 |
| C. odorata essential oil | 10 | 3.16 ± 0.13 | 3.79 ± 0.41 |
| C. odorata nanoemulgel | 10 | 4.34 ± 0.46 | 4.12 ± 0.74 |
| C. odorata nanoemulgel | 30 | 5.48 ± 0.72 | 4.90 ± 0.31 |
| C. odorata nanoemulgel | 50 | 6.92 ± 0.22 | 5.43 ± 0.87 |
| Fluconazole | 150 | 10.73 ± 0.40 | 9.42 ± 0.27 |
Disclaimer/Publisher’s Note: The statements, opinions and data contained in all publications are solely those of the individual author(s) and contributor(s) and not of MDPI and/or the editor(s). MDPI and/or the editor(s) disclaim responsibility for any injury to people or property resulting from any ideas, methods, instructions or products referred to in the content. |
© 2024 by the authors. Licensee MDPI, Basel, Switzerland. This article is an open access article distributed under the terms and conditions of the Creative Commons Attribution (CC BY) license (https://creativecommons.org/licenses/by/4.0/).
Share and Cite
Alam, P.; Imran, M.; Ali, A.; Majid, H. Cananga odorata (Ylang-Ylang) Essential Oil Containing Nanoemulgel for the Topical Treatment of Scalp Psoriasis and Dandruff. Gels 2024, 10, 303. https://doi.org/10.3390/gels10050303
Alam P, Imran M, Ali A, Majid H. Cananga odorata (Ylang-Ylang) Essential Oil Containing Nanoemulgel for the Topical Treatment of Scalp Psoriasis and Dandruff. Gels. 2024; 10(5):303. https://doi.org/10.3390/gels10050303
Chicago/Turabian StyleAlam, Perwez, Mohd Imran, Asad Ali, and Haya Majid. 2024. "Cananga odorata (Ylang-Ylang) Essential Oil Containing Nanoemulgel for the Topical Treatment of Scalp Psoriasis and Dandruff" Gels 10, no. 5: 303. https://doi.org/10.3390/gels10050303





